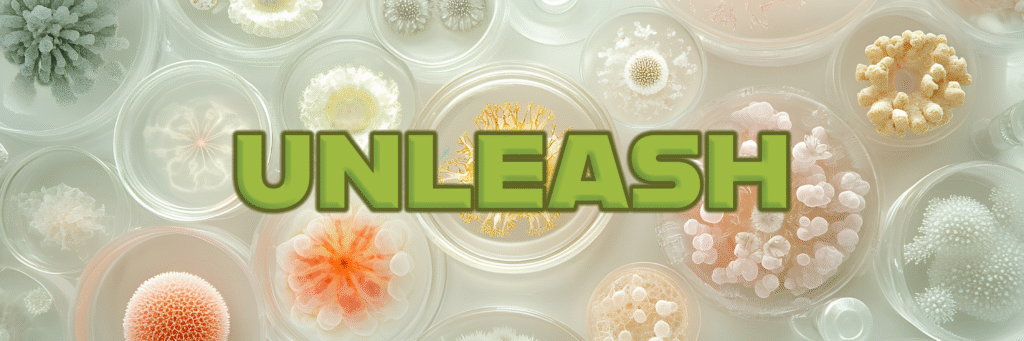

Improve Soil Microbial Diversity and Drought Management Health
Available only in the USA.

© 2025 Agro Bio USA, LLC - All Rights Reserved
(352) 531-8601
Main Office / Orders Only
(775) 346-5888
Technical Support / Warehouse Only
+1 (775) 515-5669
LATAM / International Orders Only - Available on WhatsApp.